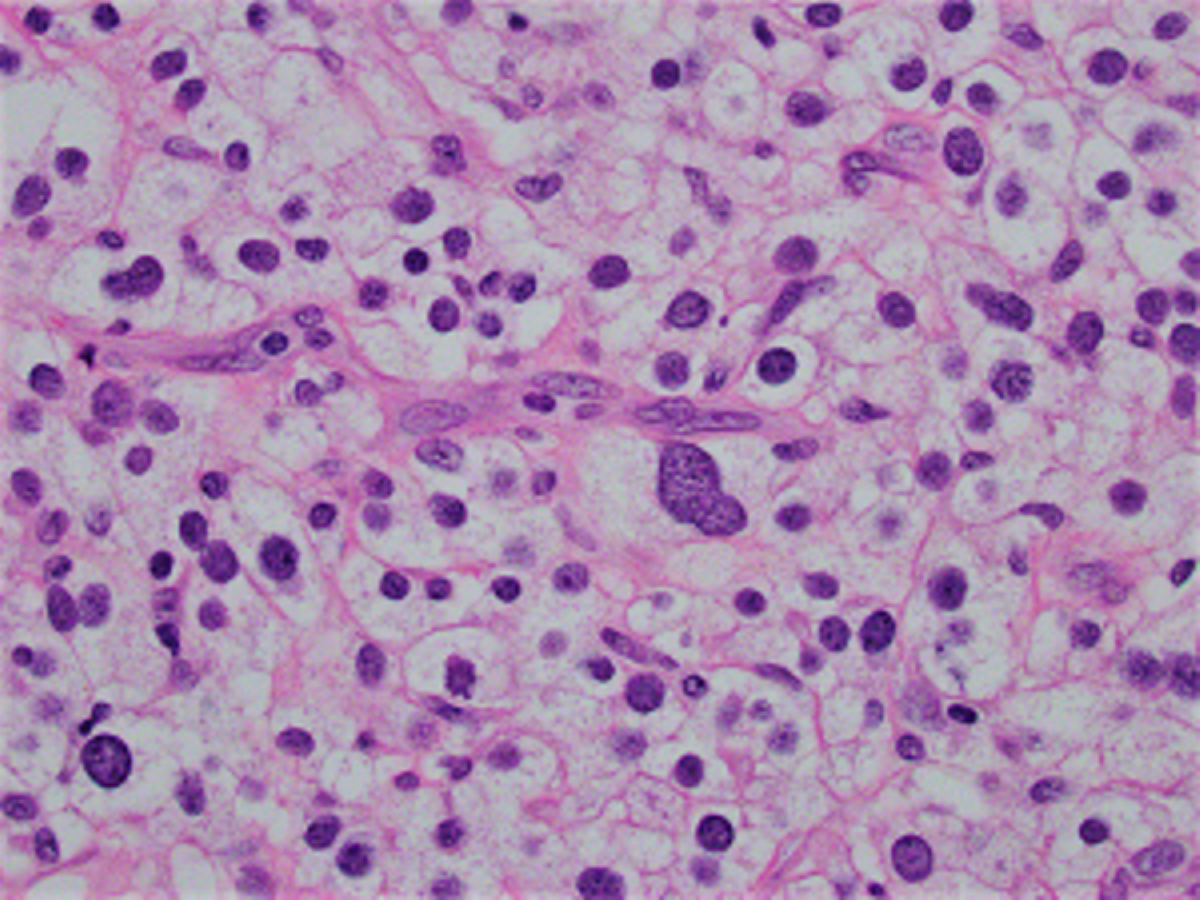

Case of the Month: Recurrent Chest Wall Mass
Case Authors: Dingani Nkosi, MBBS, PhD (PGY-1) and Aaron R. Huber, DO
Clinical History
An elderly man was referred for definitive surgical management of a recurrent right anterior chest wall mass. He had undergone wide excision of a chest wall mass 14 months prior and had started noticing rapid regrowth of the mass over the recent weeks.
Past Medical History
Significant for emphysema on oxygen.
Recent History
Imaging studies showed a large heterogeneously enhancing lesion of the anterior midline upper chest wall measuring 13.1 cm in greatest dimension and lung nodules bilaterally. The patient underwent a palliative radical excision of the chest wall mass.
Grossly, the original resection specimen revealed a 17 cm in greatest dimension firm, rubbery lesion with foci of hemorrhage and necrosis. Microscopically, the tumor was mainly composed of sheets of large epithelioid cells with clear cytoplasm and large, pleomorphic nuclei. There were areas of coagulative necrosis. Immunohistochemical stains were performed and the tumor was negative for cytokeratin, S-100, PAX8, RCC, CD10, melan-A, SMA, desmin, caldesmon and HMB-45, while diffusely and strongly positive for vimentin. The tumor recurred again and the patient underwent another chest wall resection which revealed tumor cells which were morphologically similar to the first recurrence with sheets of cells with clear cytoplasm and large, pleomorphic nuclei and foci of necrosis (Figures 1-4).